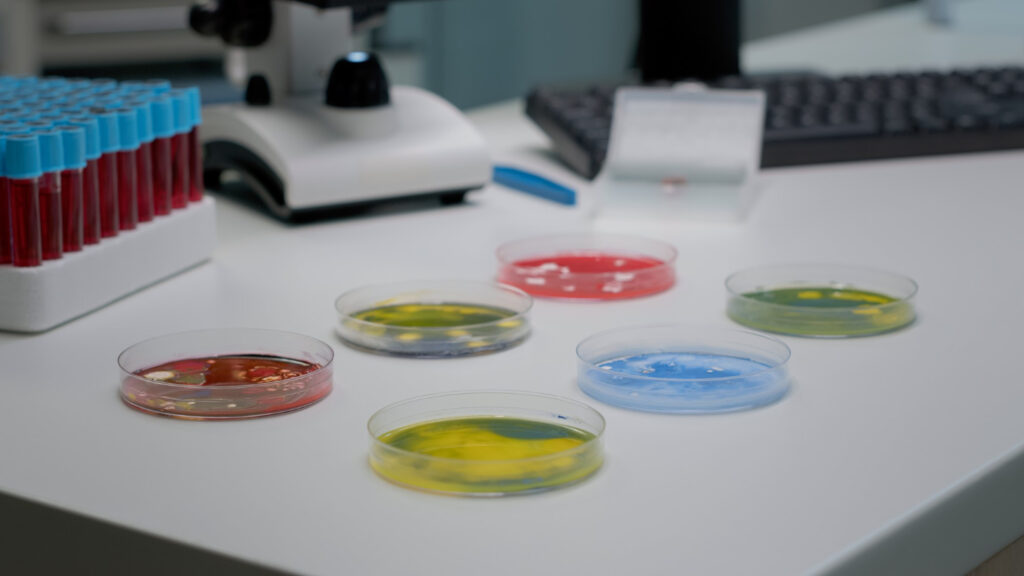

Tecnología y naturaleza
La biotecnología moderna utiliza microorganismos y genética para producir alimentos y medicamentos.
La tecnología ha usado organismos microscópicos durante milenios. La producción de cerveza y la panadería usan levaduras, organismos unicelulares que pueden vivir y multiplicarse en líquidos dulces. Sin embargo, la biotecnología moderna va más allá de estas técnicas tradicionales. El moho se utiliza ahora una antigua tecnología. La producción de cerveza es un modo de conservar los jugos y otros extractos dulces de las plantas. El gas hace que el líquido esté en efervescencia, mientras que el alcohol mata la levadura y cualquier otro organismo que crezca ahí. de proteínas. Un desarrollo muy importante ha sido la para producir antibióticos, y también se cultiva como fuente de comprensión del mecanismo de la vida. Se basa en el ADN, una excepcional molécula orgánica que puede reproducirse y controlar la producción de proteínas. La ingeniería genética-cambiar el ADN de un organismo para que se comporte diferente es una desafiante nueva tecnología que comienza.
Haciendo queso de cabra
Existen cientos de tipos de quesos, producidos cuando organismos invisibles (bacterias) invaden la leche de vaca, cabra u oveja. Muchos tipos de bacterias, algunas de ellas inofensivas parientes de organismos que causan enfermedades, pueden hacer queso. Las bacterias entran en el azúcar de la leche y la convierten en ácido, haciendo que se forme un cuajo.
Moho nutritivo
La mayoría de la gente come una variedad limitada de alimentos. Los insectos, por ejemplo, aunque son nutritivos, no son populares como alimento en la mayoría de gente, pero este rico producto, conocido como Quorn, se cocina frito, y es una fuente de proteína libre de grasas. Se deja crecer el moho en fermentadores, se extrae el agua de la infusión.
Moho protector
Mucho del sabor de los quesos tradicionales viene del moho. Los quesos frescos pueden padecer el ataque de bacterias no deseadas, pero en condiciones adecuadas, las esporas del moho (el equivalente de las semillas en el moho) se convierten en quesos maduros y crecen, matando la bacteria y formando una deliciosa corteza.
OBSERVANDO LOS GENES El ADN lleva el código químico que pasa la vida de una generación a la siguiente. Una sección del código que controla una sola característica se llama gen, y cada uno está formado por bases unidas. Todas las formas vivas se crean arreglando las mismas cuatro bases en diferentes patrones, tan distintos como libros escritos con el mismo alfabeto. Los genes se ven ahora como un patrón de líneas en una placa. Los científicos estudian cómo se relacionan los organismos, comparando sus genes.
La bacteria que salva vidas
La insulina es un mensajero químico que controla el almacenamiento de azúcares en nuestros cuerpos. Es producida por el páncreas, una glándula que está debajo del estómago, y fue descubierta por Frederick Banting (1891-1941) y Charles Best (1899-1978) en 1921. La gente que no produce suficiente insulina genera demasiada glucosa en la sangre después de comer, lo que daña su cuerpo. Una cantidad extra de insulina resuelve el problema. Se obtenía de los cerdos, pero ahora las bacterias producen insulina perfecta al unir los genes humanos con su propio ADN. La bacteria, que crece en un fermentador, produce gran cantidad del agente vital.
Cultivo in vitro
Los ingenieros genéticos pueden identificar y mover genes, pero no diseñarlos y producirlos. El mundo natural proporciona la materia prima para la biotecnología. Pero como el mundo natural está siendo destruido por otras actividades humanas, muchas organizaciones crean bancos de genes, donde se conservan características únicas de plantas y animales, para usarlas al extinguirse los proveedores naturales. Las semillas son “almacenes” de genes, pero las plantas vivas son más seguras. Las semillas de las orquídeas se hacen crecer in vitro (“en vidrio”, en latín) y se tratan casi como bebés de probeta.
Reconocimiento de la semilla
A diferencia de otras plantas, las orquídeas lanzan a sus descendientes al mundo sin un suministro de alimento envuelto en su semilla. En la naturaleza, los embriones de las orquídeas dentro de las semillas no pueden crecer sin ayuda de un hongo en particular que les proporcione nutrición adicional. Para asegurar que los genes de esa especie en peligro de extinción sobrevivan, se usan técnicas que reemplazan a los hongos. Amplificado mil veces aquí, ayuda a identificar la semilla.
CRECIENDO EN GELATINA Cuando las plantas crecen se pueden transferir sembrando la semilla. Las semillas secas y estériles se siembran en platos de a frascos. Tras varios meses las orquídeas crecen gelatina con avena como alimento. Las orquídeas bebés no pueden usar el alimento sin ayuda, así que el hongo adecuado, o un sustituto artificial, también se pone en el plato. Pero el hongo puede matar las plantitas, de modo que pronto se transfieren a otro plato. Tras varios meses las plantas crecen al tamaño que se ve aquí lo suficiente para ponerlas en macetas y manejarlas con métodos de jardinería. Cada una de los millones de células de la planta madura contendrá una copia de los genes del embrión original, mejorando las posibilidades de sobrevivir de los genes.








